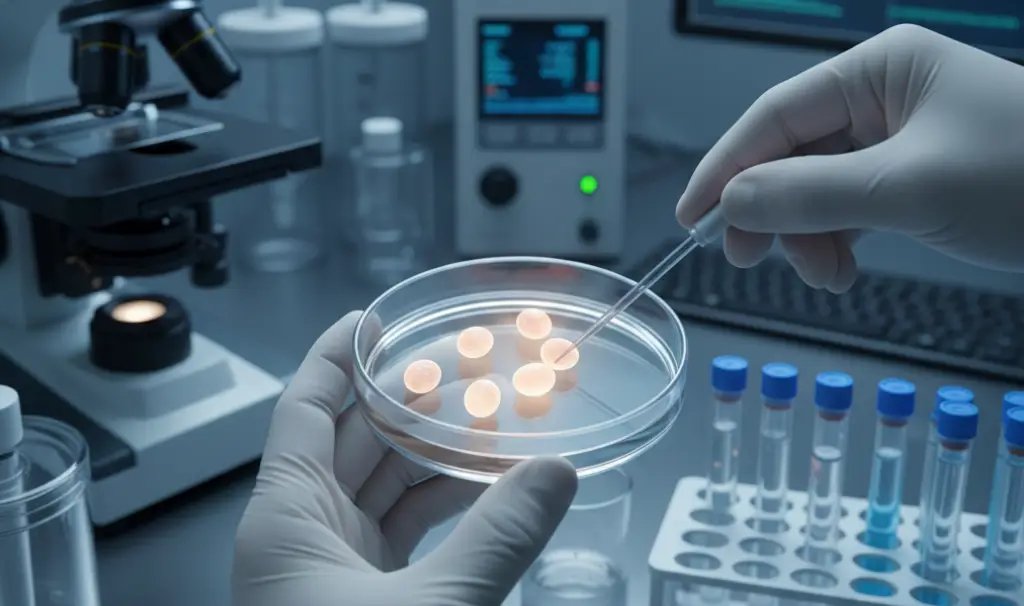
Short Term Embryology Courses Online

2 Weeks Embryology Course
2 Weeks
Yes
Hindi / English
Ready to Upgrade Your Career?
Limited seats available.
Course Structure & Learning Pathways
Short Certificate Course
- Duration: 4 Weeks
- Days: Monday, Wednesday, Friday
- Session Length: 2 Hours
- 2 Lectures (45 mins each)
- 30 mins Live Q&A
- Total 24 Lectures
- 1 Hands-on Session (Half Day)
- 1 MCQ Test (Half Day)
Comprehensive Certificate Course
- Duration: 12 Weeks
- Days: Tuesday, Thursday
- Session Length: 2 Hours
- 2 Lectures (45 mins each)
- 30 mins Live Q&A
- Total 48 Lectures
- 1 Hands-on Session (Half Day)
- 1 MCQ Test (Half Day)
Choose Your Learning Track
Course Overview
2 Weeks Short Course
Three days per week: Mon Wed Fri
2 hours per session
2 lectures 45 mins each + 30 mins Q&A
12 lectures in total
1 hands-on session (half day)
1 MCQ test (half day)
Assessment & Certification
• Module-wise quizzes
• Final MCQ examination
• Certificate on successful completion
🧪 100% Hands-On Learning
Practical training with real case-based and applied learning approach.
📜 Certification on Completion
Receive an official certificate after successful assessment.
🚀 Career-Oriented Skills
Enhance your professional credibility and career opportunities.
Why Choose ReproEvolvia?
Ideal for OBGYNs pursuing reproductive medicine.
Online learning combined with hands-on training.
Delivered by experienced infertility experts.
Step-by-step learning from basics to advanced concepts.
Aligned with Indian ART laws
Course Objectives
Understand latest infertility treatments and ART
Learn ethical, legal and social aspects
Apply evidence-based clinical decision making
Hands-on exposure with simulators
Encourage professional networking
Fundamentals of Human Reproductive Physiology

Course Structure
Module 1: Introduction to Reproductive Medicine
Duration: 1 Week
- Overview of reproductive physiology
- History and evolution of reproductive medicine
- Current trends and challenges in reproductive health

Module 2: Infertility Diagnosis and Management Pathways
Duration: 2 Weeks
- Evaluation of infertility in both men and women.
- Understanding causes of infertility and treatment options.
- Assisted reproductive technologies (ART): IVF, ICSI, and beyond.
Module 3: Reproductive Endocrinology and Hormonal Issues
Duration: 2 Weeks
- Common hormonal imbalances affecting reproduction (e.g., PCOS, thyroid disorders).
- Diagnostic approaches and therapeutic interventions.
- Impact of lifestyle factors on hormonal health.


Module 4: Emerging Technologies in Reproductive Medicine
Duration: 2 Weeks
- Latest advancements in ART and reproductive technologies.
- Role of genetics and genomics in reproductive health.
- Future directions and innovations in the ART Lab.
Module 5: Ethical and Legal Considerations
Duration: 2 Weeks
- Legal aspects related to ART, surrogacy, and donor anonymity.
- ART and Surrogacy Acts applicable in India.
- Counselling and consents as appropriate.


Module 6: Real World Case Scenarios
Duration: 2 Weeks
- Clinical case scenarios and management choices.
- Interactive discussions on case management.
- Best practices for patient communication and support.
Module 2: Infertility Diagnosis and Management Pathways
- Evaluation of infertility in both men and women.
- Understanding causes of infertility and treatment options.
- Assisted reproductive technologies (ART): IVF, ICSI, and beyond.
Module 3: Reproductive Endocrinology and Hormonal Issues
- Common hormonal imbalances affecting reproduction (e.g., PCOS, thyroid disorders).
- Diagnostic approaches and therapeutic interventions.
- Impact of lifestyle factors on hormonal health.
Module 4: Emerging Technologies in Reproductive Medicine
- Latest advancements in ART and reproductive technologies.
- Role of genetics and genomics in reproductive health.
- Future directions and innovations in the ART Lab.
Do you want to know more about our courses?
Limited seats available.
Enroll Now
Dr. Pratik Tambe
Your Instructor
Dr. Pratik Tambe MD FICOG FICRM FICMCH FIAOG is an ART consultant and Gynaec Endoscopic Surgeon. He holds a Diploma in Advanced Laparoscopic Surgery from France and has trained in Assisted Reproduction in Belgium and Clinical Embryology in the UK and Singapore. He is currently the Secretary of the Indian College of Obstetricians and Gynaecologists (ICOG) and a Governing Council member of the Indian College of Reproductive Medicine (ICRM).
